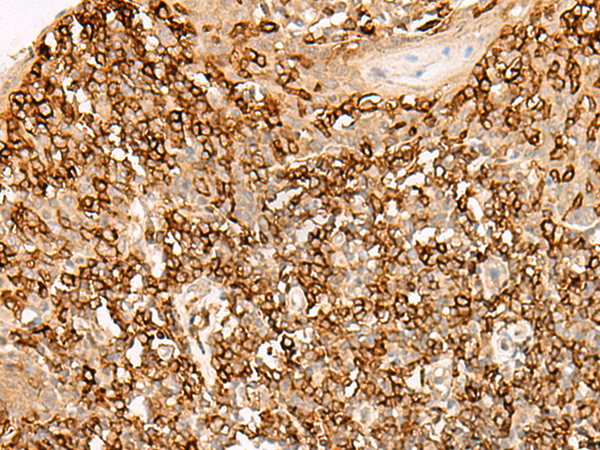
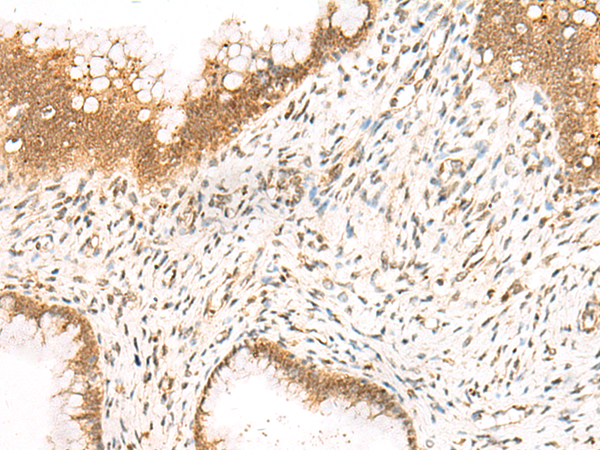

别名:ALL3; BSAP应用:WB,IHC
反应种属:Human, Mouse
规格:50μl/100μl
| Description |
|---|
| This gene encodes a member of the paired box (PAX) family of transcription factors. The central feature of this gene family is a novel, highly conserved DNA-binding motif, known as the paired box. Paired box transcription factors are important regulators in early development, and alterations in the expression of their genes are thought to contribute to neoplastic transformation. This gene encodes the B-cell lineage specific activator protein that is expressed at early, but not late stages of B-cell differentiation. Its expression has also been detected in developing CNS and testis and so the encoded protein may also play a role in neural development and spermatogenesis. This gene is located at 9p13, which is involved in t(9;14)(p13;q32) translocations recurring in small lymphocytic lymphomas of the plasmacytoid subtype, and in derived large-cell lymphomas. This translocation brings the potent E-mu enhancer of the IgH gene into close proximity of the PAX5 promoter, suggesting that the deregulation of transcription of this gene contributes to the pathogenesis of these lymphomas. Alternative splicing results in multiple transcript variants encoding different isoforms. |
| Specification | |
|---|---|
| Aliases | ALL3; BSAP |
| Swissprot | Q02548 |
| WB Predicted band size | 42 kDa |
| Host/Isotype | Rabbit IgG |
| Storage | Store at 4°C short term. Aliquot and store at -20°C long term. Avoid freeze/thaw cycles. |
| Species Reactivity | Human, Mouse |
| Immunogen | Synthetic peptide of human PAX5 |
| Formulation | pH7.4 PBS, 0.05% NaN3, 40% Glycerol |
| Application | |
|---|---|
| WB | 1/500-1/2000 |
| IHC | 1/30-1/150 |
| ELISA | 1/5000-1/10000 |
![]() |
Gel: 8%SDS-PAGE, Lysate: 40 μg, Lane 1-2: K562 and 293T cell lysates, Primary antibody: P04168(PAX5 Antibody) at dilution 1/400, Secondary antibody: Goat anti rabbit IgG at 1/5000 dilution, Exposure time: 3 minutes |
![]() |
The image is immunohistochemistry of paraffin-embedded Human tonsil tissue using P04168(PAX5 Antibody) at dilution 1/40. (Original magnification: ×200) |
![]() |
The image is immunohistochemistry of paraffin-embedded Human cervical cancer tissue using P04168(PAX5 Antibody) at dilution 1/40. (Original magnification: ×200) |
本公司的所有产品仅用于科学研究或者工业应用等非医疗目的,不可用于人类或动物的临床诊断或治疗,非药用,非食用。
暂无评论
本公司的所有产品仅用于科学研究或者工业应用等非医疗目的,不可用于人类或动物的临床诊断或治疗,非药用,非食用。
中文

发表回复